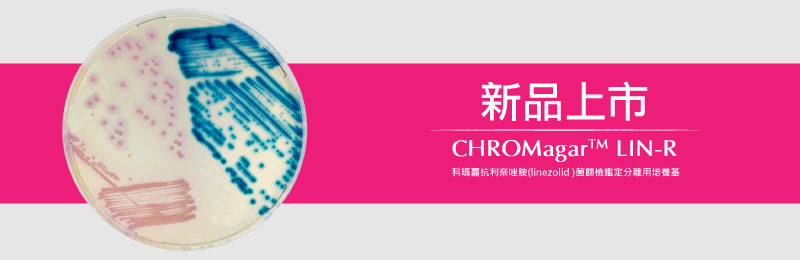

2021/06/28 新品上市-CHROMagar LIN-R 科瑪嘉抗利奈唑胺(linezolid )菌篩檢鑑定分離用培養基
|
%E6%8A%97%E8%97%A5%E6%80%A7%E8%8F%8C%E6%A0%AA_%E8%AA%AA%E6%98%8E-01.jpg) |
抗藥性革蘭氏陽性球菌的出現已對人類健康帶來了全球性的威脅。利奈唑胺(Linezolid)是一種對多種病源性革蘭氏陽性菌具有廣泛效力的抗生素,如MRSA、VRS及VRE皆可有效治療。然而,在利奈唑胺(linezolid)取得臨床應用的許可後,近期出現越來越多關於利奈唑胺抗藥性菌株(LIN-R)及cfr 基因水平轉移相關的抗藥性菌株的報導。 儘管目前利奈唑胺抗藥性菌株(LIN-R)的盛行率仍然很低,但 LIN-R 菌株的出現仍然是個很大的隱憂。現今,臨床檢體中的利奈唑胺抗藥性革蘭氏陽性菌主要是由歐洲和美國的監視計劃進行監測,而取得臨床 LIN-R 菌株的方式包括鼻拭子(用於篩查葡萄球菌)、肛周和直腸區域(用於篩查腸球菌)。 CHROMagar™ LIN-R 是一種篩選用呈色培養基,用於檢測、分離和鑑別具利奈唑抗藥性的葡萄球菌和腸球菌菌株。 |
| ►產品詳細說明:科瑪嘉 抗利奈唑胺菌 | |
| ►資訊來源:CHROMagar™ LIN-R |













